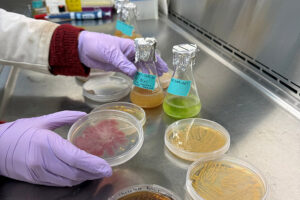

We are on a mission to inspire and empower people to value and protect water.
 Now hiring a Program Assistant for southern Minnesota
Now hiring a Program Assistant for southern Minnesota
Freshwater is hiring a Program Assistant to help implement arsenic testing and education for the Rural Health and Drinking Water project focused on private wells in eight southern Minnesota counties: Rice, Steele, Freeborn, Waseca, Faribault, Blue Earth, Watonwan and Martin. This role serves as our primary community-facing engagement coordinator in this region and supports communication and storytelling efforts that connect people to the importance of testing their wells. Learn more about this opportunity, and apply by July 20, 2026.
 Water Risk Atlas to help responsibly site large water users
Water Risk Atlas to help responsibly site large water users
With an influx of large industrial water use projects being proposed in Minnesota, Freshwater is leading work on a new geospatial tool to help municipalities, planners, communities and businesses consider how new projects might impact the water security of local communities and ecosystems. The Water Risk Atlas will be a Minnesota-specific, web-based application modeled after the World Resources Institute Aqueduct project, a widely used global mapping tool that provides insights on factors like water stress, water depletion, flooding and drought.
 Save the Date: Water Connects Us on October 22
Save the Date: Water Connects Us on October 22
We are excited to bring together supporters, partners, and new voices for an evening of connection and creativity at Water Connects Us: A Fundraiser for Freshwater, on Thursday, October 22, 2026, from 5 to 8 p.m. Make sure to mark your calendar and keep an eye out for registration to open soon.
This year’s event will center on our Art for Water initiative, exploring how creativity, community, and shared experience can deepen our connection to water and the role we all play in protecting it.
2027 Weatherguide coming soon!
The new 2027 Minnesota Weatherguide Calendar and Almanac will be available for purchase in August, here on the Freshwater website and at the Minnesota State Fair.
Published in partnership with KARE 11, Minnesota Public Radio and Jeffers Foundation, the Weatherguide features stunning photography and a wealth of information about the natural world. Plus, your purchase helps support Freshwater's work for water.
 2026 Minnesota Legislative session yields mixed results for water
2026 Minnesota Legislative session yields mixed results for water
The Minnesota Legislature adjourned on May 18 after passing a $1.24 billion bonding bill, along with relatively few water-related policy bills. Freshwater, along with our team at Park Street Public, engaged with bipartisan legislators and partners to build support for water infrastructure funding, and we backed passage of funding bills for the Outdoor Heritage Fund and the Environmental and Natural Resources Trust Fund. Visit our blog for more on the water outcomes from this year's session.
 Freshwater introduces updated strategic plan
Freshwater introduces updated strategic plan
Freshwater's 2026-2030 Strategic Plan builds on decades of science-driven impact, authentic
community engagement, and cross-sector collaboration. Our theory of change is that applied
science, focused on community needs and coordinated across sectors, leads to well-informed
policy and local action that supports healthy ecosystems, communities, and economies. Learn more about Freshwater's objectives and how we plan to accomplish our mission to inspire and empower people to value and protect water.
Innovative project harnesses the power of biology to clean up "forever chemicals" in groundwater
Innovative project harnesses the power of biology to clean up "forever chemicals" in groundwater
A bold new effort to address one of Minnesota’s most persistent water challenges is now underway. Freshwater is partnering with Bay West and the University of Minnesota on a 3-year project to develop and test innovative, biofilm-based technologies to destroy PFAS – often called “forever chemicals” – in contaminated groundwater. This project represents an important step toward long-term, science-based solutions to protect Minnesota’s water.
 View our 2025 Impact Report
View our 2025 Impact Report
We are excited to share our 2025 Impact Report, a look at the tangible progress we made together last year to inspire and empower people to value and protect water.
Thanks to Freshwater's fantastic network of supporters, 2025 was a year defined by strategic expansion of programs, timely responses to emerging water challenges, and ongoing collaboration across sectors to foster better water outcomes for all.
 Freshwater leads regional discussions on data centers and large water users
Freshwater leads regional discussions on data centers and large water users
As the use of artificial intelligence continues to rise, so does the demand for hyperscale data centers, which can use millions of gallons of water each day for cooling. State and local governments are wrestling with how to promote responsible economic development while protecting water supplies for the long term. Freshwater continues to lead regional discussions and share best practices on smart siting and design of data centers.
 Project tackles arsenic testing in southern Minnesota wells
Project tackles arsenic testing in southern Minnesota wells
Freshwater recently kicked off a new 3-year project in partnership with the Mayo Clinic to test private drinking water wells for arsenic in eight southern Minnesota counties. This pilot project (Rice, Steele, Freeborn, Waseca, Faribault, Blue Earth, Watonwan and Martin counties) approaches well testing with a new lens by partnering with healthcare physicians to educate and encourage residents to test their wells – and by offering free, convenient well testing opportunities.
 Freshwater releases second report on groundwater governance
Freshwater releases second report on groundwater governance
Freshwater recently published a new report, Towards Collaborative and Equitable Groundwater Governance in EPA Region 5, concluding our second phase of work on groundwater governance funded by The Joyce Foundation.
The report page also includes a series of related topics that the Freshwater team explored during this 18-month project such as treaties, regional and local groundwater governance, and communicating groundwater science.
 Greater Lakes Promise supports clean water through healthy lands
Greater Lakes Promise supports clean water through healthy lands
Freshwater is leading an innovative partnership for clean water called Greater Lakes Promise. With support from the Great Lakes Protection Fund, the project includes several land trusts collaborating on a regional approach to land protection around the Great Lakes.
Using state-of-the-art watershed modeling paired with local insights, our team selects high priority lands for conservation. These lands are then permanently protected with funding generated by individuals and businesses who live and work in the region.
 Fight plastic pollution with Adopt a River
Fight plastic pollution with Adopt a River
We invite you to help clean up plastics and other litter around a lakeshore, riverbank or neighborhood street near you.
Check out our Adopt a River toolkit for resources and tips on how to organize a community cleanup. It's easier than you think, and it can make a big difference. Thanks for joining together and helping keep our waters clean!

Water news and resources

Support Freshwater
Your support is instrumental in protecting the lakes, streams and drinking water we all value.
Invest in the future of clean water with a charitable gift today.
